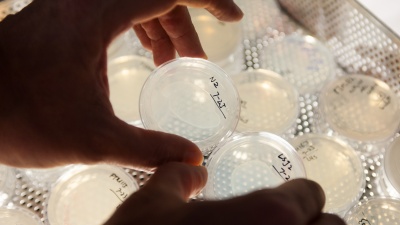
Patrick McGrath holds up dishes with two lab strains of the C. elegans roundworm. Strain LSJ2 (dish on right) dramatically changed its survival strategy to live longer and have fewer offspring due to a tiny mutation on its NURF-1 gene. Researchers at Georgia Tech confirmed the effects of the mutation by duplicating it in lab strain N2 (dish on left) via an injection with CRISPR Cas9.

Schizophrenia Simulator: When Chemistry Upends Sanity's Balance
Atlanta, GA
Working memory disturbances wreck the mental coherence of schizophrenia sufferers, yet treatments for it are very limited. Biomedical engineers have built an accurate simulator of the brain chemistry behind it to help drug developers change that.
Insights on Sex and Death from a Mutant Roundworm
Atlanta, GA
Do genetic regulators guide survival strategies in hard times? A tiny mutation in a roundworm says they may well.
Robot Helps Study How First Land Animals Moved 360 Million Years Ago
Atlanta, GA
A new study used a robot to help understand how the first land animals moved about.
Tiny Mirror Improves Microscope Resolution for Studying Cells
Atlanta, GA
A tiny mirror could make a huge difference for scientists trying to understand what’s happening in the micron-scale structures of living cells.
Gravitational Waves Detected Again
Atlanta, GA
Second Gravitational Wave detected by LIGO, which includes Georgia Tech researchers.
Heme, a Poisonous Nutrient, Tracked by ‘Green Lantern’ Sensor
Atlanta, GA
Tracking heme has dispelled a widely held assumption that it does not float freely in cellular pools.
40-Year Math Mystery and Four Generations of Figuring
Atlanta, GA
In social media and much computer technology, a field of math called Graph Theory is used to make networks work. Georgia Tech mathematicians have solved a 40-year Graph Theory mystery.
Hearing snap, crackle, pop may help heal your knee
Atlanta, GA
New acoustic device research reveals even a healthy knee makes cringeworthy sounds. But the audio can be turned into graphs, and researchers hope they will some day become medically useful.
New Technique Controls Autonomous Vehicles in Extreme Conditions
Atlanta, GA
Georgia Tech researchers have devised a novel way to help keep a driverless vehicle under control as it maneuvers at the edge of its handling limits.
Artificial Intelligence Course Creates AI Teaching Assistant
Atlanta, GA
Professor surprises students by using computer as a teaching assistant.